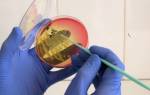

Дисфагия или затрудненное глотание – это вид функционального расстройства пищевода, при котором человек не может проглотить пищу.
Обычно, в процессе приема пищи, мы не задумываемся над процессом глотания. Забрасываем еду в рот и просто глотаем, иногда даже не успев пережевать как следует. А между тем глотание – достаточно сложный процесс. В него включены корень языка, полость глотки, мягкое небо, и кольцевые мышцы пищевода.
Но иногда мы замечаем, что в процессе глотания что-то пошло не так. Возникает ощущение, будто комок в горле застрял. Возможно также возвращение пищи из глотки в ротовую полость или боли в центре грудины. Отчего так происходит и что может являться причиной дисфагии? Попробуем разобраться в этой проблеме.
Какие могут быть причины
Наличие чувства комка в горле без изменений в процессе глотания, не является дисфагией. Такое проявление наблюдается в случае поражения щитовидной железы, нервно-психических расстройств и стенокардии.
В определенных случаях человеку трудно глотать лишь твердую пищу. При тяжелом течении чувство кома в горле сохраняется постоянно и мешает даже проглатывать слюну. Основными признаками дисфагии является:
- незначительный кашель во время приема пищи;
- ощущение присутствия инородного тела в верхних дыхательных путях;
- частая отрыжка, причем через нос;
- потеря веса;
- затрудненное дыхание, одышка.
Нарушение глотания развивается на уровне пищевода или ротоглотки. Это зависит от причины возникновения проблемы. Прогноз в лечении патологии различный. Чаще полностью возвращаются утраченные функции, но в определенных случаях питание возможно в дальнейшем только через зонд.
Классификация и степени
Относительно локализации патологического процесса выделяют:
- Орофарингеальную (ротоглоточную) дисфагию – при этом наблюдаются трудности в переходе пищи из глотки в пищевод. Развивается из-за патологий мышц глотки, окологлоточных мышц или нервных заболеваний.
- Эзофагеальную (пищеводную) дисфагию – возникает по причине перекрытия просвета пищевода либо нарушенного движения его мышц. Условно разделяется на нижнюю, верхнюю и среднюю.
- Крикофарингеальную дискоординацию – является несогласованным сокращением круговых волокон верхнего пищеводного сфинктера.
- Дисфагию, возникающую из-за передавливания пищевода крупными сосудами, проходящими рядом (аорта и ее ветви). Развивается в случае патологий этих сосудов.
Существуют также 4 степени заболевания:
- Трудно проглатывать только твердую пищу.
- Невозможно употреблять твердую пищу; с мягкой и полужидкой при этом трудностей не возникает.
- Человек способен есть исключительно жидкую пищу.
- Полная невозможность совершать акт глотания.
Вероятные факторы
Самым распространенным этиологическим фактором являются возрастные изменения. У пожилых людей происходят атрофические явления в мышцах, отвечающих за акт глотания.
Также особое влияние оказывают такие хронически заболевания как ХОБЛ, ксеростомия слизистой оболочки рта, различные поражения носоглотки и ротовой полости.
Физиологический акт глотания
Все причины можно разделить на несколько групп. Их клинические признаки достаточно схожи, поэтому диагностику должен проводить только врач.
Невралгические факторы
Это проблемы, развивающиеся в нервной системе человека. Они напрямую связанны с функционированием спинного и головного мозга. К таким заболеваниям относится:
- инсульт;
- опухолевидные поражения головного и спинного мозга;
- болезнь Паркинсона;
- деменция;
- рассеянный склероз;
- тяжелая миастения.
Врожденные факторы
Это причины, которые уже формируются в процессе еще внутриутробного развития ребенка. Вызвать чувство комка в горле могут вызвать следующие патологии:
- детский церебральный паралич;
- расщелины губы и неба;
- нарушение функций обучаемости.
Обструкция дыхательных путей и пищевода
Некоторые заболевания способны не только вызывать ощущения инородного тела в глотке, но и серьезно затруднять прохождение пищи и жидкости. Из наиболее опасных следует выделить следующие:
- Инфекционные заболевания. Наиболее часто проблему вызывают туберкулез и кандидоз. Они вызывают воспаление пищевода, что в свою очередь провоцируют обструкцию. Даже обычное воспаление в виде фарингита, может быть причиной проблемы.
- Рак полости рта или верхних дыхательных путей, а также пищевода. Если лечение прошло успешно, то все симптомы проходят достаточно быстро.
- Последствия лучевой терапии. После такого воздействия могут образовываться рубцы, которые дают симптоматику комка в горле.
- Гастроэзофагеальный рефлюкс. Из-за постоянного затекания содержимого желудка в область пищевода, происходит раздражение слизистой оболочки.
Заболевания мышечных тканей
Такие поражения встречаются довольно редко. Они связанны с заболеваниями, которые поражают мышечную ткань и нарушают проталкивание пищи в желудок.
В основном это такие поражения как:
- Склеродермия. При данном состоянии иммунная система атакует здоровые клетки. В результате повреждаются мышцы пищевода и гортани.
- Ахалазия пищевода. Связанно с недостаточным расслаблением мышечной ткани в нижних отделах пищевода.
Краткая анатомия
В процессе нормального глотания принимают участие 26 мышц, все они иннервируются 5 черепно-мозговыми нервами. Глотание разделяется на три фазы:
- Ротовая фаза. Данная стадия начинается по завершению пережевывания пищи, когда пищевой комой смещается до уровня глотки. По времени занимает меньше 1 секунды. Является единственным компонентом глотания, который сознательно контролируется корой головного мозга.
- Глоточная фаза. На этом этапе происходит мягконебное глоточное закрывание, поднимается гортань, защита дыхательных путей и перистальтического движения грудки вниз по глотке, обходя уровень открытой перстневидноклеточной глоточной мышцы. Фаза контролируется рефлекторно центром глотания, расположенным в продолговатом мозгу. Ее длительность меньше 1 секунды.
- Пищеводная фаза. Заключается в действии силы тяжести совместно с координированным и прогрессирующим сокращением мускулатуры пищевода, происходит перемещение грудки вниз к желудочно-пищеводному сфинктеру. Как правило, длится 8-20 секунд.
Методы диагностики проявления кома в горле
Чтобы выявить дисфагию и ее этиологические факторы, в первую очередь обращаются к терапевту или педиатру, если проблема возникла у ребенка. После первичного осмотра врач направляет уже к узкому специалисту для лечения основной патологии.
Тест на проглатывание воды
Методами исследования для определения проблемы могут быть следующие:
- Тест проглатывание воды. Пациенту дают 150 мл воды, которую необходимо выпить в течение определенного времени.
- Видеофлюроскопия. Данная методика схожа с обычным рентгенологическим исследованием. Отличие ее в том, что процедура проведения записывается и ее можно просмотреть повторно. Перед исследованием пациенту дают выпить бариевую взвесь, которая помогает определить непроходимость пищевода.
- Манометрия. Методика позволяет оценить работу пищевода, при помощи специального катетера.
- Суточный мониторинг pH. Измеряется кислотность желудка при помощи специального оборудования.
- Гастроскопия. Обследование внутренних структур пищевода и желудка.
- Оценка питания. В процессе исследования измеряют вес, рост и рассчитывают индекс массы тела.
Как оказать первую помощь, если человек подавился?
Существует несколько основных правил и приемов, которых стоит придерживаться, чтобы произвести первую медицинскую помощь. Необходимо похлопать между лопаток человека. Это поможет в том случае, если он кашляет.
Как оказать первую помощь, если человек подавился:
- Это означает, что кусочки пищи частично перекрыли дыхательные пути, трахею, поэтому часть воздуха поступает, но в достаточном количестве. Может наблюдаться синева в области нижней губы. Это означает, что кислорода недостаточно.
- Мало кто знает, как правильно выполнять эти постукивания. Чаще всего наносятся сильные удары кулаком, когда человек находится в положении стоя. Это неправильно, и лишь усугубляет ситуацию, проталкивая кусочки пищи еще глубже в дыхательные пути.
- В таком случае их будет сложнее удалить. Поэтому оптимальным вариантом является попросить человека нагнуться вперед, и нанести удары ладонью в области между лопатками. Необходимо, чтобы движения были по направлению от поясницы к шее. То есть как бы выталкивающими и скользящими, а не прямыми похлопываниями.
Поперхнулся
Некоторые моменты в лечении кома в горле
Дисфагия пищевода
Практически все случаи дисфагии поддаются лечению. Даже вовремя выявленные опухолевидные образования злокачественного характера, можно устранить успешно и надолго. Лечение во многом зависит от того каково поражение у больного.
Рак горла
Случайно поперхнулась слюной, не могу откашляться: что делать?
В таком случае предоставить первую медицинскую помощь некому, придется спасать себя самостоятельно. Главное в этой ситуации – не паниковать.
Случайно поперхнулась слюной, не могу откашляться, что делать:
- Конечно, чаще всего человек теряется, у него состояние стресса, не совсем отдает отчет, что необходимо делать. Однако существуют простые манипуляции, которые помогут извлечь кусочки пищи из дыхательных путей. Для этого возьмите стул и поставьте его.
- Обопритесь грудной клеткой на спинку, таким образом, чтобы она находилась в области между нижними ребрами и пупком. Теперь попытайтесь наклоняться таким образом, чтобы спинка стула стучала в этой области.
- Свесьте голову вперед таким образом, чтобы образовался уклон, кусочки пищи с легкостью покинут гортань. Если это не помогает, можете самостоятельно выполнить прием Геймлиха. Для этого необходимо положить в область диафрагмы ладонь, согнутую в кулак.
- При этом вторая рука должна обхватить этот кулак. Теперь наносите удары снизу вверх, при этом наклоняйтесь вперед. Таким образом, вы создадите благоприятные условия, чтобы кусочки пищи покинули трахею.
Терапия ротоглоточной дисфагии
Когда проблема связанна с неврологическими изменениями, то лечить их чрезвычайно трудно. В основном все воздействие будет ограниченно облегчением приема пищи больному.
Рекомендуется изменить рацион питания, провести переобучение методики глотания, в тяжелых случаях осуществление зондового кормления.
Средства для лечения комка в горле при голотании
Если комок в горле при глотании формируется из-за заболеваний верхних дыхательных путей, то может быть назначена антибактериальная, противовирусная и антисептическая терапия. Такие заболевания как тонзиллит, фарингит, ларингит вполне поддаются лечению.
Но это делать надо вовремя, так большинство данных заболеваний дают тяжелые осложнения на сердечнососудистую систему и опорно-двигательный аппарат.
Иногда комок в горле может формироваться при аллергических реакциях. Они могут быть на различные факторы. В лечении в этом случае важно выявить аллерген и провести антигистаминную терапию.
Терапия пищевой дисфагии
Нередко лечебные процедуры в этом случае врач назначает на дом. Они заключаются в основном в соблюдении некоторых ограничений в питании и приеме специальных лекарственных веществ:
- Блокаторы протонного насоса: позволяют снять воспалительный процесс в органах пищеварения. Успешно устраняют спазм и при развитии гастрорефлюксе.
- Блокаторы кальциевых каналов.
- Спазмолитики и нитраты: применяются при ахалазии пищевода.
- Бутолотоксин: используется в случае мышечных спазм.
Когда появляется комок в горле при глотании, это не значит, что развивается тяжелая болезнь. Очень часто такое состояние связанно с обычными воспалительными процессами в верхних дыхательных путях. Чтобы исключить тяжелые заболевания, следует пройти обследование и уточнить диагноз.
Отличная статья 1
Как убрать проблему с глотанием?
Проблемы с глотанием на нервной почве бессмысленно лечить препаратами от простуды и даже спазмолитиками. Единственная мишень, в которую нужно целиться при лечении, – это страх. Фобия умереть, задохнуться, захлебнуться, подавиться насмерть. Страх смерти не проходит сам по себе. Можно лишь спрятать его глубоко, под несколькими слоями бытовых дел и любимых занятий, но он будет постоянно напоминать о себе, как скребущаяся мышка в тёмном погребе. От страха смерти ВСДшник боится глотать и конечно сразу же при этом ему сразу становится трудно глотать даже слюну. Это как если бы вы сильно боялись паука — вам было бы трудно к нему прикоснуться.
Лучший эффект в такой ситуации дают психотерапевтические беседы с грамотным психологом для устранения причины проблемы. Работа над собой – обязательный элемент комплексного лечения. Пока пациент не поймёт, что имеет психологическую проблему, препараты бессмысленны. Даже антидепрессанты в таком случае не окажут должного эффекта. Да, на время лечения пациент почувствует себя лучше, спокойнее, но как только курс прекратится, всё вернётся во круги своя.
Специалисты советуют попробовать смириться со своим страхом, разрешить себе бояться. Ведь чем упорнее мы убегаем от пугающих событий, тем сильнее мы начинаем бояться их. Страх, который больше не питается вашими эмоциями, ослабнет и прекратит давить изнутри.
Если у вас только недавно начались проблемы с глотанием, то важно как можно раньше начать работу с психологом. Чем раньше это сделать, тем проще убрать причины страха глотать. Если же запустить проблему, то зачастую она только усугубляется. Становиться страшно глотать пищу и даже пить воду.
Инсульт
Среди всех причин смерти инсульт занимает второе место. В зависимости от этиологии, то есть причины возникновения, заболевание делится на два типа. Ишемический инсульт является следствием нарушений, вызывающих ухудшение кровоснабжения участков головного мозга. Геморрагический тип подразумевает излитие крови из сосудистого русла.
К инсульту могут привести следующие причины:
- артериальная гипертензия;
- сахарный диабет;
- заболевания сердца;
- курение;
- избыточный вес;
- алкоголизм;
- хронический стресс.
Заболевание чаще всего проявляется в виде асимметрии лица. Человек даже не может улыбнуться. Развивается полная или частичная потеря зрения. У пациента возникают затруднения в разговоре или понимании речи. Наблюдается внезапная головная боль. Присутствует слабость в руке, ноге или одной половине туловища. В качестве осложнения инсульта развивается нарушение глотания.
Опухоли
Условно новообразования разделяют на два типа: доброкачественные и злокачественные. Чаще всего они развиваются из лимфаденоидных тканей, т.е. гланд, задней стенки глотки и мягкого неба. Несвоевременное оперирование пациента и прохождение лучевой терапии может стать причиной летального исхода. Поэтому при обнаружении гипертрофии небных миндалин и стенок глотки следует обратиться за помощью к врачу.
Типы опухолей:
- эпителиома – опухоль, возникающая из эпителиальных клеток на слизистых оболочках ЛОР-органов; по мере разрастания патологических тканей дискомфортные ощущения постепенно усиливаются;
- лимфосаркома – злокачественное новообразование, которое образуется из клеток лимфоидного ряда; поражает слизистую оболочку глотки и регионарные лимфоузлы;
- ретикулосаркома – опухоль, возникающая в результате бесконтрольного деления гистацитов;
- рак щитовидной железы – злокачественное новообразование, которое возникает из фолликулярных клеток.
Проявлениями онкологического заболевания чаще всего являются боль в глотке и шее, затрудненное глотание слюны, сиплость голоса, отдышка и спастический кашель. Точно определить тип патологии может только специалист после получения результатов гистологического анализа, полученного при обследовании тканей, взятых из опухоли.
Болеть горло может и в результате травмирования слизистых оболочек воздухоносных путей твердыми предметами, летучими химикатами, сигаретным дымом и т.д. Запоздалая обработка раневых поверхностей антисептическими препаратами может стать причиной септического воспаления ЛОР-органов. Условно травмы разделяют на три категории:
- химический ожог – самый опасный вид травмы, возникающий вследствие проникновения реагентов, концентрированных кислот и щелочей в слизистую оболочку ЛОР-органов; ожог мягких тканей вызывает сильные боли и может стать причиной кровотечения;
- термический ожог – употребление горячих чая, кофе и других напитков может привести к ожогу мерцательного эпителия и лимфоидных тканей, выстилающих поверхность ротоглотки; эрозивные образования и язвы вызывают в пациента сильные боли при напряжении мышц глотки и глотании слюны;
- механические травмы – проникновение в глотку инородных предметов – рыбных косточек, стекол, металлической стружки и т.д., приводит к механическому повреждению слизистых оболочек ЛОР-органов и, как следствие, септическому воспалению горла.
Несвоевременное устранение отечности в горле может стать причиной удушья.
Самое важное
Дисфагия – это нарушение акта глотания. Проблемы возникают при употреблении твердой и мягкой пищи. Это не самостоятельное заболевание, а следствие какого-то уже имеющегося в организме патологического процесса. У взрослых дисфагия часто возникает на фоне инсульта. В детском возрасте нарушение глотание часто диагностируется наряду с церебральным параличом.
Имеются случаи внезапного появления дисфагии, но чаще расстройство возникает постепенно, на фоне патологических процессов. Расстройство глотания может оказаться смертельно угрозой. Проблемы во время проглатывания пищи являются серьезным поводом обращения к специалисту. Возможно, что причина дисфагии потребует экстренной помощи.
Как избавиться от неприятного запаха из ротовой полости
В первую очередь при возникновении данного симптома необходимо обратиться к врачу, провести тщательное обследование для выявления причины появления запаха или привкуса гноя, и начать лечение диагностированного заболевания.
- При пародонтите, альвеолите и абсцессах челюстно-лицевой области назначаются антимикробные препараты широкого спектра действия (Амоксиклав, Азитромицин) курсом на 5-7 дней в стандартных терапевтических дозировках, витаминотерапия, общеукрепляющее и симптоматическое лечение. Неприятный запах проходит после полного выздоровления и санации очага инфекции.
- Если причиной привкуса во рту является хронический тонзиллит с образованием гнойных пробок в миндалинах, проводится процедура по их удалению при помощи медицинского шпателя или специального аппарата «Тонзиллор». После удаления тонзиллярных камней производится обработка антисептическим раствором, накладываются антибактериальные мази.
- Использование различных физиотерапевтических процедур, направленных на купирование воспаления и ускорение процесса выздоровления (при абсцессах, тонзиллитах, периодонтитах). Широко используются электро- и фонофорез, УВЧ.
- При выявлении инородного тела, ставшего причиной гнойного воспаления носовых ходов, производится его удаление и назначение лекарственных средств, способствующих восстановлению слизистой оболочки.
В домашних условиях можно использовать следующие методы:
- Ополаскивание ротовой полости антисептическими растворами (Хлоргексидин, Мирамистин, Фурацилин).
- Полоскания отварами лекарственных трав, обладающих противомикробным и противовоспалительным действием (ромашка, шалфей, календула, мелисса).
- Прием лекарственных препаратов, повышающих местный и общий иммунитет (Иммунал, Имупрет, Интерферон), способствует сокращению срока течения заболевания и предотвращению развития осложнений.
- Соблюдение достаточной гигиены с использованием зубной нити, ополаскивателей, ирригатора.
При возникновении вкуса гноя необходимо обратиться к специалисту и не заниматься самолечением, поскольку неприятный запах изо рта может являться одним из симптомов многих серьезных заболеваний, без должного лечения часто приводящих к развитию осложнений.